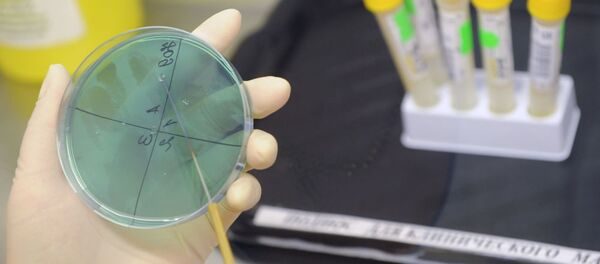
اقدامات وزارت بهداشت ایران درباره آنفلوآنزای مرغی - اسپوتنیک ایران

در اوایل سال جاری، در سفارت ایران در مسکو یادداشت سه جانبه در مورد شروع صادرات تست Diaskintest امضا شد. در ماه آوریل 2018، وزارت بهداشت ایران میزبان یک جلسه وسیع کمیته فنی ملی تشخیص و درمان سل بود که در آن تست روسی برای تشخیص سل و شامل کردن آن در برنامه های دولتی بررسی شد.
پیشتر تست Diaskintest در سازمان بهداشت جهانی WHO معرفی شد. این تست روسی به عنوان یک راه حل مدرن برای مشکل جهانی تشخیص سل شناخته شد. دمیتری کودلای مدیر کل شرکت روسی جِنِریوم در مصاحبه با اسپوتنیک، در مورد منحصر به فرد بودن تست روسی برای تشخیص سل و جذابیت آن برای ایران، روند متقابل انتقال تکنولوژی و مشکلات مرتبط با آن، و نیز امکان صادرات داروها برای درمان امراض نادر و دارای اهمیت اجتماعی سخن گفت.
— سؤال: چه طرفی مبتکر این مذاکرات بود؟
— جواب: ابتکار مذاکرات با ایران بود، زیرا موفقیت فدراسیون روسیه در مبارزه با سل در سراسر جهان در بالاترین سطح قبول شده است. اولین کنفرانس جهانی WHO در ماه نوامبر سال 2017 در مسکو به قصد از بین بردن این بیماری تا سال 2030 برگزار شد و نمایندگانی از 194 کشور در آن حضور داشتند، این را تأیید کرد. از اواسط سال 2017، ما به طور مداوم با همتایانمان ایرانی، هم در تهران، و هم در مسکو و استان ولادیمیر، جایی که پایگاه علمی و تولیدی ما واقع شده است، ملاقات می کنیم.
— سوال: این تست از چه نظر برای ایران منحصر بفرد است؟
— جواب: تست روسی Diaskintest نه تنها برای ایران بلکه برای کل جهان منحصر بفرد است. این پیشرفت اصلی دانشمندان روسی هیچ مشابهی در جهان ندارد و در مقایسه با روش های دیگر، یک تشخیصی ساده بوده و قیمت آن پایین است.
— سوال: فایده توافق حاصله برای جنریوم چیست؟ علاقه شرکت شما به بازار دارویی ایران برای چیست؟
— جواب: جا دارد گفته شود که در حال حاضر، ایران در زمینه بیوتکنولوژی دارای صلاحیت کافی است و در این صورت، راه — دو طرفه است. یادداشت امضا شده، علاوه بر تأمین منابع Diaskintest، همچنین به انتقال متقابل فن آوری ها اشاره می کند. این امر به نفع شهروندان دو کشور در دسترسی مطمئن به مواد دارویی تولید شده با کاربرد تکنولوژی پیشرفته خواهد بود.
— سوال: در پاییز سال 2017، وزارت بهداشت ایران دیاسکینتست را ثبت کرده و در حال حاضر پروسه وارد کردن دارو در برنامه های دولتی در حال انجام است. آیا Diaskintest تا به حال به ایران وارد شده است؟
— جواب: در حال حاضر جنریوم آماده می شود تا مطالعات متقابل تست در ایران را انجام دهد، هدف اصلی این است که پرسنل پزشکی را با روشی برای کاربرد آن آشنا کنیم.
— سوال: موعد اجرایی شدن توافق چه وقت است؟
— جواب: توافقنامه امضا شده دراز مدت است، زیرا نه تنها تحویل بلکه انتقال مرحله به مرحله فن آوری های تولیدی را در نظر دارد که می تواند حدود 5 سال طول بکشد.
— سوال: چه داروهای دیگری به ایران وارد می شوند؟
— جواب: در چارچوب این توافقنامه، در سالهای آینده، برنامه هایی برای تأمین داروهای ما برای درمان بیماری های نادر و دارای اهمیت اجتماعی مانند هموفیلی، بیماری گوشه، فیبروز سیستیک و دیگر موارد در نظر گرفته می شود.
— سوال: شرکت شما انتقال مرحلهای تکنولوژی به ایران را برنامه ریزی می کند. آیا این شرکت در رونمایی و ترویج این فناوری ها به ایران کمک خواهد کرد؟
— جواب: روند انتقال فناوری برای تولید داروهای بیوتکنولوژی بسیار طولانی و پیچیده است. برای انجام موفق این کار نقشه راه مرحلهای در دست طرحریزی است. در این طرح آموزش کارشناسان ایرانی و ورود متخصصان ما برای کار در ایران در نظر گرفته شده است. جنریوم در حال حاضر از تجربه انتقال تکنولوژی خود به خارج از کشور برخوردار است، بنابراین ما کار خود را در ایران با استفاده از تجربیات اندوخته شده به خوبی انجام خواهیم داد.
— سوال: شرکای ایرانی شما در انتقال فن آوری از بخش خصوصی یا دولتی اند؟ چه کسی این پروژه را تامین پولی می کند؟
— جواب: از طرف ایران، شرکت های داروسازی بزرگ مشارکت دارند، اما در عین حال وزارت بهداشت جمهوری اسلامی نیز به ما کمک زیادی می کند.
— سوال: آیا داروها و فن آوری های ایران هم به روسیه ارائه شده است؟
— جواب: ما کیف حاوی پیشنهاد های طرف ایرانی را بس جذاب تلقی میکنیم تا آنها را در ضمیمه توافق بررسی کنیم.